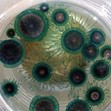

Загадъчни сини създания нападнаха плажовете на САЩ
- Редактор: Кристиян Великов
- Коментари: 0
Летовниците по плажовете на Северна Каролина били принудени да споделят пясъчната ивица със загадъчни сини подобни на медузи същества.
Порпитите, или известни още като „сини копчета“, били изхвърлени на брега от вълните. Макар че този вид не е рядък в местността, те обикновено не се виждат често.
„Не се виждат често, защото обикновено плуват в открития океан. Няколко пъти в годината виждаме как порпитите идват към брега с бурите или силните ветрове“, казва Брайън Дорн от океанариума на остров Роанок.
Порпитите са океански пелагичен вид хидроиди, които не се отнасят към медузите. Малките „сини копчета“ (с диаметър на тялото 2,5 см) са безобидни. Макар че подобните им на пипалца хидроиди жилят, то е толкова леко, че хората дори не го забелязват.
„Сините копчета“ обикновено обитават топлите води на Гълфстрийм, но се озовават по плажовете от ветровете на крайбрежните бури. Въпреки че на бреговете на Северна Каролина не са отбелязвани силни бури, крайбрежните системи с ниско налягане са образували вълни, които са отнесли порпитите на брега.

Бойко Борисов: Ще строим фабрики за изкуствен интелект
КНСБ: Търговците надуват цените с над 100% надценка
КНСБ: Търговците надуват цените с над 100% надценка
КНСБ: Търговците надуват цените с над 100% надценка
КНСБ: Търговците надуват цените с над 100% надценка